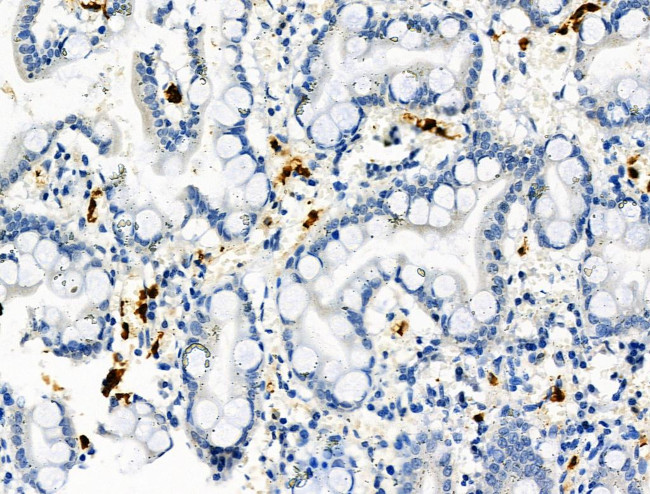
Phospho-RRAS (Tyr66) Antibody in Immunohistochemistry (Paraffin) (IHC (P))

Search
Invitrogen
Phospho-RRAS (Tyr66) Polyclonal Antibody
{{$productOrderCtrl.translations['antibody.pdp.commerceCard.promotion.promotions']}}
{{$productOrderCtrl.translations['antibody.pdp.commerceCard.promotion.viewpromo']}}
{{$productOrderCtrl.translations['antibody.pdp.commerceCard.promotion.promocode']}}: {{promo.promoCode}} {{promo.promoTitle}} {{promo.promoDescription}}. {{$productOrderCtrl.translations['antibody.pdp.commerceCard.promotion.learnmore']}}
图: 1 / 7
Phospho-RRAS (Tyr66) Antibody (PA5-118783) in IHC (P)







Please note: We are reviewing Western blot images included in the antibody testing data in our catalog, including those provided by third parties. Unless expressly labeled or annotated as “raw-unedited”, Western blot images included in the antibody testing data in our catalog may have been edited, optimized or otherwise adjusted for presentation.
产品信息
PA5-118783
种属反应
宿主/亚型
分类
类型
抗原
偶联物
形式
浓度
规格
纯化类型
保存液
内含物
保存条件
运输条件
RRID
产品详细信息
Antibody detects endogenous levels of R-Ras only when phosphorylated at Tyr66.
靶标信息
The Ras superfamily of small GTPases includes the Ras, Rho, Arf, Rab, and Ran families. Ras-regulated signal pathways control such as actin cytoskeletal integrity, proliferation, differentiation, cell adhesion, apoptosis, and cell migration. These GTPases function as molecular switches that control eukaryotic cell function by cycling between two interconvertible forms, a GDP-bound inactive form and a GTP-bound active form. The binding of GTP leads to a conformational change in the downstream effector-binding domain of the G-protein. The small GTPases are monomeric G-proteins with molecular masses over the range 20-30 kDa. Ras is attached to the cell membrane by prenylation. Mutations in the Ras family of proto-oncogenes (comprising H-Ras, N-Ras and K-Ras) are very common, being found in 20% to 30% of all human tumours. The frequency of RAS mutations is among the highest for any gene in human cancer. K-ras mutations occur frequently in non-small-cell lung, colorectal, and pancreatic carcinomas; H-ras mutations are common in bladder, kidney, and thyroid carcinomas; N-ras mutations are found in melanoma, hepatocellular carcinoma, and hematologic malignancies.
仅用于科研。不用于诊断过程。未经明确授权不得转售。
篇参考文献 (0)
生物信息学
蛋白别名: Harvey rat sarcoma oncogene, subgroup R; Harvey rat sarcoma virus oncogene, subgroup R; p23; Ras-related protein R-Ras; Ras-related protein R-RAS (P23)
基因别名: AI573426; p23; RRAS
UniProt ID: (Rat) D3Z8L7, (Mouse) P10833
Entrez Gene ID: (Rat) 361568, (Mouse) 20130